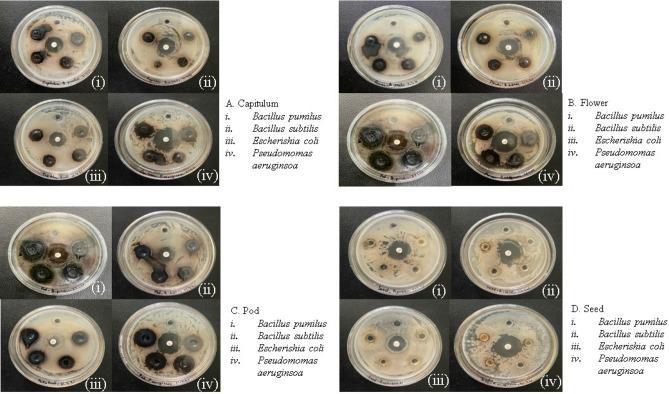

GC-MS 和分子对接分析表明,来自未充分利用的植物 Parkia timoriana 的植物化学物质可能具有抗癌和抗炎作用。
GC-MS and molecular docking analyses of phytochemicals from the underutilized plant, Parkia timoriana revealed candidate anti-cancerous and anti-inflammatory agents.
机构信息
Department of Botany, Mizoram University, Aizawl, Mizoram, 796004, India.
Department of Horticulture, Aromatic and Medicinal Plants, Mizoram University, Aizawl, Mizoram, 796004, India.
出版信息
Sci Rep. 2022 Mar 1;12(1):3395. doi: 10.1038/s41598-022-07320-2.
Plants are excellent sources of functionally bioactive compounds and essential nutrients. The phytochemical constituents have enormous potential in treating both plant and human diseases. Parkia timoriana (Yongchak/Zawngtah), one of the most important underutilized plants popularly consumed in Manipur and Mizoram states of Northeastern region of India, is known for its ethnobotanical and ethnomedicinal values. A significant DPPH (2,2-diphenyl-1-picrylhydrazyl), ABTS (2,2'-azino-bis (3-ethylbenzothiazoline-6-sulfonic acid)), and Phosphomolybdate scavenging activity corresponding to high antioxidant potentials was shown by the extracts from different edible parts of P. timoriana. P. timoriana extract showed significant antibacterial potential against Bacillus pumilus, Bacillus subtillis, Escherichia coli and Pseudomonas aeruginosa. Fourier transform infrared spectroscopy and gas chromatography-mass spectrometry (GC-MS) analyses of the extracts revealed the functional groups and bioactive compounds present in different edible parts of the plant. Characteristic peaks of phenols, carboxylic acids, alkenes, glycogen, alkyl halides, halogen, aliphatic amines, primary and secondary amines, esters, ether, aromatics, lipids, triglycerides, nitro compounds that had antimicrobial, anti-cancer and anti-inflammatory properties etc. were observed. The GC-MS analysis also revealed the occurrence of 49 bioactive compounds that are known to possess a variety of pharmacological activities. Subsequently, in silico molecular docking studies of the identified bioactive compounds predicted potential anticancer and anti-inflammatory properties. To the best of our knowledge, this is the first-hand report on the bioactive compounds of edible parts of P. timoriana extracts showing antioxidant, antimicrobial and pharmacological significance. This study can lead to the production of new herbal medicines for various diseases employing P. timoriana and perhaps leading to the creation of new medications.
植物是具有生物活性的功能化合物和必需营养物质的重要来源。植物化学物质在治疗植物和人类疾病方面具有巨大的潜力。Parkia timoriana(Yongchak/Zawngtah)是印度东北部曼尼普尔邦和米佐拉姆邦广泛食用的最重要的未充分利用植物之一,以其民族植物学和民族医学价值而闻名。从不同可食用部分提取的 P. timoriana 提取物表现出显著的 DPPH(2,2-二苯基-1-苦基肼)、ABTS(2,2'-联氮-双(3-乙基苯并噻唑啉-6-磺酸))和磷钼酸盐清除活性,对应高抗氧化能力。傅里叶变换红外光谱和气相色谱-质谱(GC-MS)分析提取物表明,不同可食用部分存在功能基团和生物活性化合物。观察到酚类、羧酸类、烯烃、糖原、烷基卤化物、卤素、脂肪族胺、伯胺和仲胺、酯、醚、芳烃、脂类、甘油三酯、具有抗菌、抗癌和抗炎等特性的硝基化合物等特征峰。GC-MS 分析还显示了 49 种生物活性化合物的发生,这些化合物已知具有多种药理学活性。随后,对鉴定出的生物活性化合物进行了计算机分子对接研究,预测了潜在的抗癌和抗炎特性。据我们所知,这是关于 P. timoriana 可食用部分提取物的生物活性化合物的第一手报告,显示出抗氧化、抗菌和药理学意义。这项研究可以导致使用 P. timoriana 生产各种疾病的新草药,并可能导致新药物的产生。